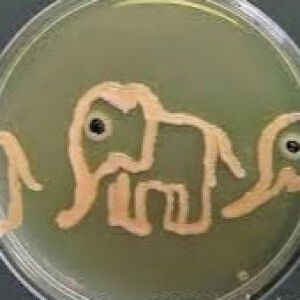
Suci Latief profile icon

berat badan
Berat badan bayi 7 bulan
2 Tanggapan
Latest
Recommended

Tulis tanggapan
anak saya lahir BBLR dgn BB 1,8 kg, sekarang udh 7 bulan bb nya sekarang 6,5 apakah aman bb segitu untuk anak yg lahir BBLR?
Tergantung pb nya bunn, bukan dari usia lagi
Pertanyaan Terkait